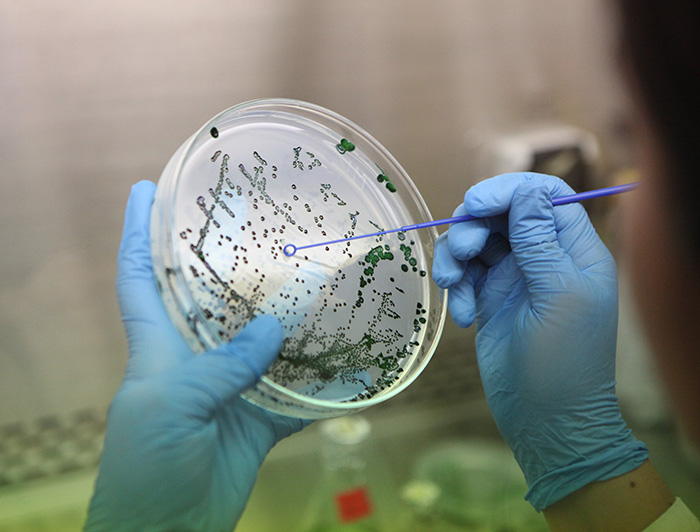

Nuevo fondo público apoyará innovaciones sustentables lideradas por académicos UC
Un suplemento alimenticio en base a algas y un sistema de conversión de energía para la producción ecológica de hidrógeno en base a energía fotovoltaica, son los dos proyectos liderados por investigadores de la UC que obtuvieron financiamiento del primer concurso de Tecnologías Avanzadas, promovido por la ANID, y que busca apoyar proyectos de I+D que requieran ciclos largos en sus etapas de investigación.

photo_camera Como afirma el director de Transferencia y Desarrollo de la UC, Álvaro Ossa: “Este programa es una gran noticia para el ecosistema de innovación nacional, porque entrega recursos relevantes para que equipos de investigación puedan avanzar en la validación de sus tecnologías, reduciendo el riesgo de su transferencia al mercado. (Crédito fotográfico: iStock Photo)
Los profesores Mónica Vásquez de la Facultad de Ciencias Biológicas, y Javier Pereda de la Facultad de Ingeniería, lideran los proyectos de la UC ganadores de la primera versión del Concurso “Tecnologías Avanzadas” impulsado por la Agencia Nacional de Investigación y Desarrollo (ANID).
El objetivo de este programa inédito es apoyar financieramente el desarrollo de proyectos de investigación aplicada y de desarrollo tecnológico, que requieran ciclos largos en sus etapas de investigación para la validación de tecnologías a nivel de prototipo a pequeña escala, acorde a la envergadura de su ámbito de aplicación.
El vicerrector de Investigación Pedro Bouchon, comenta que “gracias a este nuevo programa de financiamiento público, los resultados de investigación que se realizan en las universidades chilenas estarán más cerca resolver problemas del sector socio-productivo e impactar positivamente en la sociedad”.
Tres son las líneas de investigación propuestas por el concurso:
• Descarbonización justa: el desarrollo tecnológico para una industria sostenible de hidrógeno verde y la generación de demanda local de H2V; impulso a la descarbonización de industrias locales y al desarrollo tecnológico de almacenamiento de energías renovables.
• Resiliencia a la crisis climática y sus impactos ambientales: se promueve la I+D+i para enfrentar la crisis hídrica, la adaptación a los cambios climáticos y el desarrollo de infraestructuras verdes y soluciones basadas en la naturaleza.
• Diversificación productiva sostenible: desarrollo de vacunas y biofármacos a nivel local, impulsando la seguridad y soberanía alimentaria y el desarrollo sostenible de la industria del litio en toda su cadena de valor.
“Este programa es una gran noticia para el ecosistema de innovación nacional, porque entrega recursos relevantes para que equipos de investigación puedan avanzar en la validación de sus tecnologías, reduciendo el riesgo de su transferencia al mercado. Si buscamos generar un real impacto basado en ciencia y tecnología, la mirada a largo plazo en estos temas es central”, explica Álvaro Ossa, director de Transferencia y Desarrollo UC, unidad que apoyó la postulación de estos proyectos al fondo público.
El concurso entrega un financiamiento de hasta $637.800.000 millones de pesos a los ganadores, y tiene un plazo de ejecución de hasta 48 meses. En esta primera versión resultaron ganadores 10 iniciativas presentadas por universidades a lo largo de país.
Producción sustentable de suplementos alimenticios
El equipo liderado por Mónica Vásquez está desarrollando una solución para la producción sustentable de suplementos alimenticios rico en omega-3 obtenido a partir de microalgas.
Esta innovación busca ofrecer un recurso alimenticio apto para consumo de animales y humanos, incluido el público vegano, ya que reemplaza los ingredientes de origen animal -como la harina y el aceite de pescado-, los que son recursos no renovables y han registrado un aumento considerable de sus precios en los últimos años.
La académica de Ciencias Biológicas explica el impacto de esta adjudicación en el desarrollo de su tecnología: “Nos va a permitir construir una planta piloto que asegure la producción constante de microalga, además de realizar ensayos de escalamiento. También podremos financiar todos los estudios preclínicos en distintos modelos animales. Por otro lado, nos permitirá incorporar postdoctorados, estudiantes de posgrado y pregrado, contribuyendo a la formación de capital humano”
El aporte de Tecnologías Avanzadas, según detalla Mónica Vásquez, dará continuidad al proyecto, avanzando en los estudios preclínicos y una versión inicial de los estudios clínicos, todo esto con el fin de llevar un producto al mercado. Asimismo, el equipo liderado por la Universidad Católica y codesarrollado en conjunto con la Universidad Santo Tomás, ya se encuentra preparando una solicitud de patente.
A propósito de esta misma innovación, Mónica Vásquez estuvo hace pocas semanas en Boston, Estados Unidos, en el marco de Global UC, programa impulsado por la Dirección de Transferencia y Desarrollo, y Ciencia 2030, que busca crear capacidades emprendedoras en los equipos académicos de la universidad, con el fin de acercar sus innovaciones al mercado.
Producción ecológica de hidrógeno

Un sistema de conversión de energía para la producción ecológica de hidrógeno utilizando energía fotovoltaica, es el proyecto que desarrollará el equipo liderado por el académico Javier Pereda.
Las tecnologías de almacenamiento de energía desempeñan un papel clave en la aceleración de la descarbonización y transición a energías renovables. En función de lo anterior, esta innovación consiste en un sistema de conversión de energía para la producción ecológica de hidrógeno, utilizando energía fotovoltaica y un sistema de almacenamiento de energía mediante un volante de inercia (pieza que continúa su movimiento por inercia cuando cesa el motor que lo propulsa).
Este sistema presenta ventajas frente a las baterías, ya que tiene mayor capacidad de ciclos de carga y descarga, menores costes de funcionamiento y mantenimiento, y mejor vida útil. Esta solución, además, requiere de una única etapa de conversión, conectando las tres tecnologías directamente, lo que reduce las pérdidas de energía y los costes.
“Ya presentamos una patente PCT (sistema internacional de patentes) y ahora estamos inscribiéndola para patentarla en Chile y en Estados Unidos. Esto significa que vamos a poder probar la tecnología ya en un sistema más cercano a la realidad, más cercano al pilotaje, porque hasta ahora ha sido probada la tecnología en laboratorio con sistemas reales funcionando. Con el programa Tecnologías Avanzadas ya tenemos financiamiento para comprar sistemas reales, donde se va a conectar la tecnología y probar su funcionamiento en entornos que alcanzan un nivel más cercano a un nivel comercial”, comenta el profesor de Ingeniería.
Las líneas de investigación del profesor Pereda han sido apoyadas por los programas de financiamiento de Hubtec, recibiendo además acompañamiento en las tramitaciones de protección intelectual desde la Dirección de Transferencia y Desarrollo de la Vicerrectoría de Investigación.
Siguientes pasos
Este nuevo instrumento de apoyo a la I+D ofrecido por la ANID, viene a ofrecer un ciclo de ejecución y financiamiento mayores a otras fuentes de financiamiento, con lo cual los proyectos tienen un período de trabajo más amplio y presupuesto para realizar desarrollo a una mayor escala.
De acuerdo a las bases del concurso IDeA I+D Tecnologías Avanzadas, se espera obtener resultados de producción, como prototipos, productos o servicios, próximos a ser transferidos y/o escalados. Asimismo, se espera la generación de publicaciones, propiedad intelectual y formación de capital humano.





